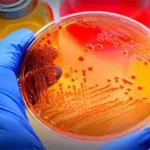

آزمایش مونو تست یکی از روشهای تشخیصی است که برای بررسی عفونت ویروسی مونونوکلئوز یا مونو به کار میرود. این عفونت در اثر ویروس اپشتین بار (EBV) ایجاد میشود که جزء خانواده تبخالها است. این ویروس به راحتی از طریق بزاق به دیگران منتقل میشود و علائم شبیه آنفلوآنزا را در بدن ایجاد میکند. در این مقاله قصد داریم به شما آشنایی بیشتری با آزمایش Monotest بدهیم و نحوه انجام، تفسیر و کاربرد آن را توضیح دهیم.
آزمایش مونو تست چیست؟
آزمایش مونو تست یک آزمایش خون ساده است که با گرفتن نمونه خون از بازو یا پا انجام میشود. نمونه خون به آزمایشگاه فرستاده شده و در آنجا با چندین واکنش شیمیایی روبرو میشود. هدف از این واکنشها جستجو و شناسایی آنتی بادیهای خاص است که در صورت وجود عفونت EBV در بدن تولید میشوند. این آنتی بادیها به نام آنتی بادی هتروفیل (Heterophile Antibody) شناخته میشوند و نشان دهنده فعال بودن سیستم ایمنی در برابر ویروس هستند.
در آزمایش مونو تست چه مواردی بررسی میشود؟
آزمایش مونو یک آزمایش خونی است که به دنبال وجود آنتیبادیها یا نشانگرهای دیگری میگردد که بدن به منظور مقابله با این ویروس تولید کرده است و بهتر است حتما در بهترین آزمایشگاه در تهران انجام شود.

مواردی که در آزمایش مونو ممکن است بررسی شوند عبارتند از:
1. آنتیبادیهای ویروس اپشتین-بار (EBV): آزمایش بررسی میکند که آیا بدن شما آنتیبادیهایی که برای مبارزه با ویروس اپشتین-بار تولید میکند، دارد یا خیر.
2. آمینوترانسفراز (ALT) و آسپارتات آمینوترانسفراز (AST): این آزمایشات برای اندازهگیری سطح آنزیمهای کبدی در خون صورت میگیرد. بیماری مونو ممکن است منجر به افزایش این آنزیمها در خون شود.
3. پایش سلولهای خونی: گاهی اوقات آزمایشات خونی برای بررسی تعداد و نوع سلولهای خونی (مانند لنفوسیتها) نیز انجام میشود، زیرا بیماری مونو میتواند تعداد لنفوسیتها را افزایش دهد.
آزمایش مونو نوکلئوز معمولاً برای تشخیص بیماری مونوکلئوز در صورت شک مطرح میشود، زیرا علائم این بیماری میتواند مشابه علائم سایر بیماریها باشد. در صورتی که افراد علائمی مانند تب، گلو درد، بیماریهای گوارشی و خستگی ناشی از تورم طولانیمدت لنفوگردها داشته باشند، پزشک ممکن است آزمایش مونو را تجویز کند تا بیماری مونوکلئوز را تایید یا رد کند.
بیشتر بخوانید: تست ایمنی شناسی بدن
شرایط انجام آزمایش مونو تست چگونه است؟
برای انجام آزمایش مونو (آزمایش تشخیص بیماری مونوکلئوز)، معمولاً نیاز به نمونه خون است. این آزمایش معمولاً توسط یک پرستار یا پزشک در محیط بالینی یا آزمایشگاه انجام میشود.
مراحل انجام آزمایش مونو ممکن است شامل موارد زیر باشد:
1. جمعآوری نمونه خون: نمونه خون از رگ شما در ناحیه بازو جمعآوری میشود. پرستار یا پزشک از سوزن و لولههای خون جهت جمعآوری نمونه استفاده میکند.
2. آنالیز نمونه: نمونه خون به آزمایشگاه ارسال میشود. در آزمایشگاه، نمونه تحت آزمونهای مختلف برای بررسی آنتیبادیهای ویروس اپشتین-بار (EBV) یا دیگر نشانگرهای مرتبط با بیماری مونوکلئوز قرار میگیرد.
3. گزارش نتایج: پس از آنکه آزمایشات انجام شد، نتایج به پزشک شما ارائه میشود. پزشک نتایج را بررسی کرده و به شما توضیح میدهد.
برای آمادهسازی انجام این آزمایش، ممکن است پزشک شما توصیههای خاصی داشته باشد، اما به طور کلی این آزمایش نیازی به فضای ویژه یا آمادهسازی خاصی از جانب شما ندارد. از پزشک خود مشورت کنید تا در مورد نکات خاصی که قبل از آزمایش باید رعایت کنید یا هرگونه دستورات پیش آزمایشی اطلاعات بیشتری بگیرید.
تفسیر آزمایش مونو تست
آزمایش مونو تست دارای دو نتیجه مثبت یا منفی است. نتیجه مثبت به این معناست که آزمایشگاه آنتی بادی هتروفیل را در خون شما پیدا کرده است. این نشان دهنده احتمال بالای عفونت EBV و بروز مونو است. البته در برخی موارد، نتایج غلط مثبت هم رخ میدهد؛ به عبارت دیگر، شخص عفونت EBV ندارد، اما آزمایش نشان داده است که دارد. این مورد در صورت وجود سایر عفونتها، سرطانها، لوپوس و حالات دارورسان (Drug-induced) احتمال دارد.
بالعکس، نتیجه منفی به این معناست که آزمایشگاه هتروفیل را در خون شما پیدا نکرده است. این نشان دهنده احتمال کم عفونت EBV و بروز مونو است. البته در برخی موارد، نتایج غلط منفی هم رخ میدهد؛ به عبارت دیگر، شخص عفونت EBV دارد، اما آزمایش نشان نداده است که دارد. این مورد در صورتی احتمال دارد که شخص در مراحل اولیه یا پایانی عفونت باشد و سطح آنتی بادی هتروفیل در خون کافی نباشد.
بیشتر بخوانید: آزمایش آنزیم های کبدی
چه زمانی پزشک آزمایش مونو تست تجویز میکند؟
پزشک ممکن است آزمایش مونو (آزمایش تشخیص بیماری مونوکلئوز) را در نظر بگیرد در مواردی که علائم مشخص و شایع بیماری مونوکلئوز مانند نفخ، گلو درد، تب، خستگی شدید و تورم طولانی مدت لنفوگردها در نقاطی مانند گردن و محلولات درون بدنی دیده شوند.
اگر علائم شما به بیماری مونوکلئوز اشاره دارد، پزشک ممکن است آزمایش مونو را تجویز کند تا بیماری را تایید یا رد کند. بیماری مونو معمولاً به طور زیادی به ویروس اپشتین-بار (EBV) مرتبط است، بنابراین آزمایش برای تشخیص حضور آنتیبادیهای مربوط به این ویروس در خون انجام میشود.
علاوه بر این، آزمایش مونو ممکن است در مواردی که بیمار به شدت احساس خستگی کند و علائم مشابه بیماری مونوکلئوز داشته باشد، تجویز شود؛ اما این ممکن است در تعیین دقیق دلیل خستگی ناشی از عوامل دیگر نیز مفید باشد.
پزشک شما بر اساس علائم و عوارضی که شما دارید و بررسی بالینی خود، تصمیم به تجویز یا عدم تجویز این آزمایش میگیرد.
آزمایش مونو تست در منزل قابل انجام است؟
بله آزمایش مونو تست در منزل قابل انجام است. برای این کار، شما میتوانید از خدمات آزمایش در منزل برخی از آزمایشگاهها استفاده کنید. به عنوان مثال، آزمایشگاه سیمرغ این خدمت را ارائه میدهد. برای درخواست آزمایش Mono Test در منزل، شما باید به سایت آزمایشگاه سیمرغ مراجعه کنید و فرم درخواست را پر کنید. سپس یک پرستار یا پرسنل آزمایشگاه در زمان و مکان مورد نظر شما حضور خواهد یافت و نمونه خون شما را جهت انجام تست گرفته و به آزمایشگاه منتقل خواهد کرد. نتیجه تست شما در عرض چند ساعت به صورت آنلاین در دسترس شما قرار خواهد گرفت.
سخن آخر
در آزمایش مونو، نمونه خون از بیمار گرفته میشود و سپس در آزمایشگاه، نمونه خون برای بررسی آنتیبادیهایی که بدن به منظور مقابله با ویروس اپشتین-بار تولید میکند، تحلیل میشود.
این آزمایش میتواند به تایید یا رد بیماری مونوکلئوز کمک کند. اگر نتایج مثبت باشند، این نشاندهنده حضور آنتیبادیهای مربوط به ویروس EBV است که نشان میدهد بیمار به این ویروس عفونت داشته است یا هنوز هم با آن عفونت دارد.